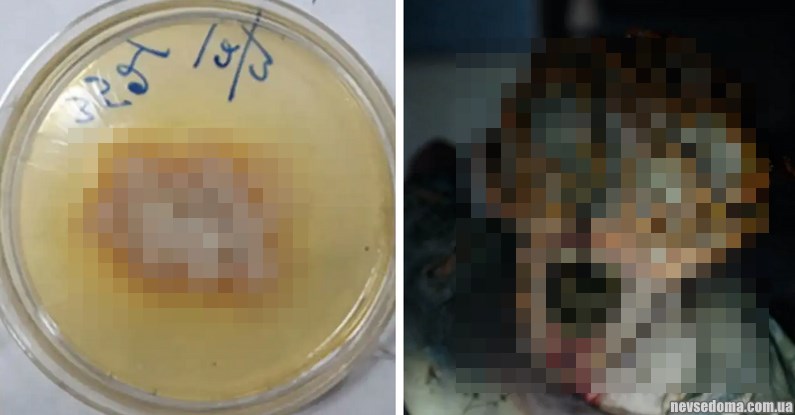
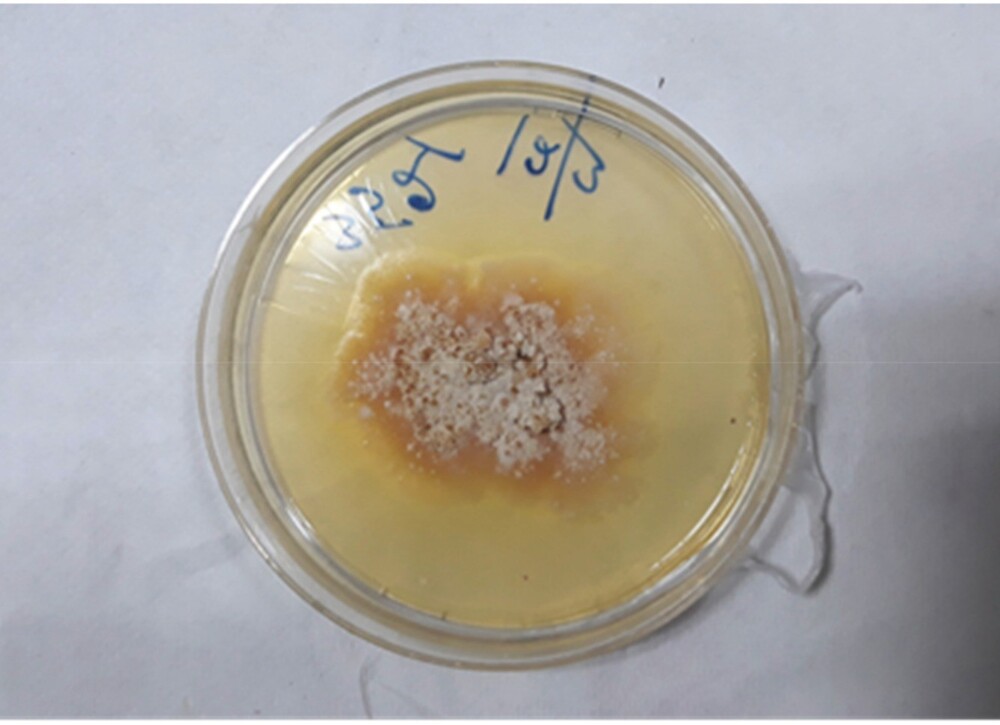

"One of us. Beginning": in India, a killer fungus for the first time in history infected a person (5 photos)
It looks like the new popular series "The Last of Us" filed mushrooms Idea: A 61-year-old Indian man was struck by the same fungal infection that causes "silver leaves" - a disease that kills deciduous trees.
Fortunately, we are unlikely to see an analogue in the near future. cordyceps, which captures the brains of those infected in the aforementioned series, however, this case in India still raises concerns: scientists are concerned potential emergence of new diseases. 
“The fact that plant pathogens can cause disease in animal and human, is a new concept that raises serious questions,” writes Dr. Soma Datta of General Hospital Apollo in Calcutta. The pathogen enters the human body through damaged skin and respiratory tract and can cause infection in mostly in immunocompromised people. Interregional human pathogens and plants as potential reservoirs may have serious consequences in the form of the emergence of new infectious diseases." 
The patient's name has not been released, but it is known that he, as a mycologist, he worked with decaying mushrooms. The patient started cough and had difficulty swallowing food for three months, after which he went to a hospital in Calcutta complaining of hoarseness and sore throat. Doctors found a small hole in the lymph knots at his windpipe, but they were puzzled by the negative test results for bacterial infection. Further analyzes a sample of pus from the patient's throat showed it to be a fungus, and the sample had to be sequenced in the laboratory of the World Organization health care to determine the strain of the fungus.
Doctors completely removed the pus and prescribed a course for the patient antifungal drugs for two months, which cured the infection. Behind the last two years the fungus in the patient was no longer observed. His case described in Medical Mycology Case Reports is the first reported case of human infection with a plant fungus.
"Silver leaves" is a fungal disease of plants and deciduous trees, caused by chondrostereum purpureum, the same the fungus that infected the patient. The fungus spreads through airborne spores and infects the leaves of plants and trees, turning them silver, then killing them. 
Last year, WHO warned that the number of deaths fungal infections are on the rise, posing a threat to humanity. Many fungal pathogens, including candida, which causes such common infections like vaginal candidiasis are on the rise more resistant to treatment. Despite this, fungal infections very little attention and resources are given to research. At present there are only four classes of antifungal drugs, and very few new drugs are in development.


















